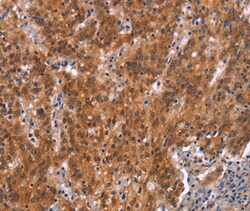
Invitrogen GNAT3 Polyclonal Antibody 100 &mu;L; Unconjugated:Antibodies,

missing translation for 'onlineSavingsMsg'
Learn More
Learn More
Invitrogen™ GNAT3 Polyclonal Antibody


Rabbit Polyclonal Antibody
Brand: Invitrogen™ PA550670
This item is not returnable.
View return policy
Description
The antibody detects endogenous levels of total GNAT3 protein.
Guanine nucleotide-binding protein (G protein) alpha subunit playing a prominent role in bitter and sweet taste transduction as well as in umami (monosodium glutamate, monopotassium glutamate, and inosine monophosphate) taste transduction. Transduction by this alpha subunit involves coupling of specific cell-surface receptors with a cGMP-phosphodiesterase; Activation of phosphodiesterase lowers intracellular levels of cAMP and cGMP which may open a cyclic nucleotide-suppressible cation channel leading to influx of calcium, ultimately leading to release of neurotransmitter. GNAT3 can functionally couple to taste receptors to transmit intracellular signal: receptor heterodimer TAS1R2/TAS1R3 senses sweetness and TAS1R1/TAS1R3 transduces umami taste, whereas the T2R family GPCRs act as bitter sensors. Functions also as lumenal sugar sensors in the gut to control the expression of the Na+-glucose transporter SGLT1 in response to dietaty sugar, as well as the secretion of Glucagon-like peptide-1, GLP-1 and glucose-dependent insulinotropic polypeptide, GIP. Thus, may modulate the gut capacity to absorb sugars, with implications in malabsorption syndromes and diet-related disorders including diabetes and obesity.
Specifications
| GNAT3 | |
| Polyclonal | |
| Unconjugated | |
| GNAT3 | |
| alpha-gustducin; G protein subunit alpha transducin 3; GDCA; Ggust; Gnat3; gnat-3; Gtn; guanine nucleotide binding protein, alpha transducing 3; guanine nucleotide-binding protein G(t) subunit alpha-3; gustatory G protein; gustducin alpha-3 chain; gustducin, alpha polypeptide | |
| Rabbit | |
| Antigen affinity chromatography | |
| RUO | |
| 242851, 286924, 346562 | |
| -20°C | |
| Liquid |
| Immunohistochemistry (Paraffin), Western Blot | |
| 1.4 mg/mL | |
| PBS with 40% glycerol and 0.05% sodium azide; pH 7.4 | |
| A8MTJ3, P29348, Q3V3I2 | |
| GNAT3 | |
| Synthetic peptide corresponding to residues near the N terminal of human guanine nucleotide binding protein, alpha transducing 3. | |
| 100 μL | |
| Primary | |
| Human, Mouse, Rat | |
| Antibody | |
| IgG |
Product Content Correction
Your input is important to us. Please complete this form to provide feedback related to the content on this product.
Product Title
Spot an opportunity for improvement?Share a Content Correction